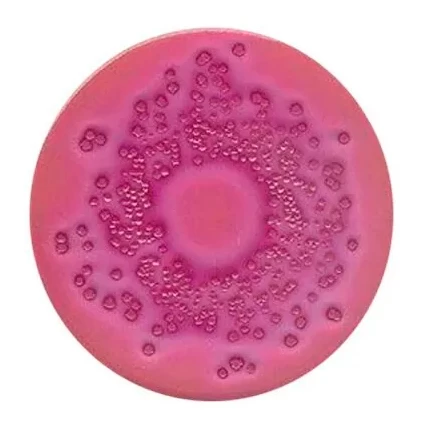

Изображение может отличаться от оригинала, не влияя на характеристики товара. Производитель может изменить информацию без предварительного уведомления.
Весь товар сертифицирован.
Назначение
- для выделения и учета энтеробактерий в пищевых продуктах.
Состав:
рН 7,3±0,2 при 25°С.
- мясной пептон - 7 г/л.
- дрожжевой экстракт - 3 г/л.
- хлорид натрия - 5 г/л.
- глюкоза - 10 г/л.
- смесь солей желчных кислот - 1,5 г/л.
- нейтральный красный - 0,03 г/л.
- кристаллический фиолетовый - 0,002 г/л.
- агар-агар - 13 г/л.
Особенности:
- Глюкозный агар с кристаллическим фиолетовым и желчью. Селективная среда, предложенная Мосселем (1962, 1963) для выделения и учета энтеробактерий в пищевых продуктах.
- Состав среды согласован с рекомендациями ISO (1977), Bundesminister fur das Gesundheitswessen (1967), EP 11 и §35 LMBG по исследованию продуктов питания.
Принцип действия
- Кристаллический фиолетовый и соли желчных кислот подавляют сопутствующую микрофлору.
- Глюкоза расщепляется с образованием кислоты, при этом цвет индикатора меняется на красный, образуются зоны преципитации желчных кислот вокруг колоний.
- Обнаруживаются все энтеробактерии, поскольку они разлагают глюкозу с образованием кислоты.
- Питательная среда, однако, не абсолютно специфична для этих микроорганизмов, т.к. некоторые сопутствующие бактерии (например, Aeromonas) также проявляют эти признаки роста.
Способ приготовления:
- Растворить 39,5 г среды в 1 литре дистиллированной воды, дать среде набухнуть в течение 20-30 минут, нагревать при частом перемешивании до полного растворения.
- После этого кипятить не более 2 минут.
- Среду нельзя автоклавировать или перегревать!
Характеристики:
- Объем: 250 гр.
- Готовая среда прозрачная, темно-красного цвета. Инкубировать 24ч при 35°С, аэробно. Идентификацию энтеробактерий следует подтвердить дополнительными тестами.
Для покупки товара в нашем интернет-магазине выберите понравившийся товар и добавьте его в корзину. Далее перейдите в Корзину и нажмите на «Оформить заказ» или «Быстрый заказ».
Когда оформляете быстрый заказ, напишите ФИО, телефон и e-mail. Вам перезвонит менеджер и уточнит условия заказа. По результатам разговора вам придет подтверждение оформления товара на почту или через СМС. Теперь останется только ждать доставки и радоваться новой покупке.
Оформление заказа в стандартном режиме выглядит следующим образом. Заполняете полностью форму по последовательным этапам: адрес, способ доставки, оплаты, данные о себе. Советуем в комментарии к заказу написать информацию, которая поможет курьеру вас найти. Нажмите кнопку «Оформить заказ».
Мы работаем:
- с физическими лицами;
- с юридическими лицами.
Мы принимаем:
- оплату картой на сайте;
- оплату по счету.
Доставка по Москве и России партнерскими службами доставки
- СДЭК,
- ПЭК,
- Деловые линии,
- Байкал-сервис.
Осуществляется после оплаты заказа, стоимость доставки клиент оплачивает при получении.
Информация о стоимости доставки партнёров является справочной и может быть изменена!
Услуги за перевозку груза по России транспортной компанией до ближайшего пункта выдачи или по адресу в вашем городе оплачиваются при получении!
Стоимость и возможность доставки у разных компаний могут отличаться!
Курьерская доставка Дезнэт по Москве (за МКАД по согласованию).
- заказ от 2000 до 2500 рублей - 450 рублей.
- заказ от 2500 рублей - бесплатно.
Обратите внимание, доставка по Москве - до подъезда, подъем не осуществляется!
Самовывоз
ПОЖАЛУЙСТА, НЕ ПОСЕЩАЙТЕ СКЛАД, ЕСЛИ ВАШ ЗАКАЗ НЕ СОГЛАСОВАН!
Адрес
г. Москва, Кавказский бульвар д. 60, стр. 1.Режим работы склада
Пн-Чт. с 9:00 до 17:00,
Пт. с 9:00 до 16:00,
Сб. с 10:00 до 15:00.
Окончательная стоимость товаров и доставки будут сформированы при подтверждении заказа менеджером.
Изображение может отличаться от оригинала, не влияя на характеристики товара. Производитель может изменить информацию без предварительного уведомления.
Весь товар сертифицирован.